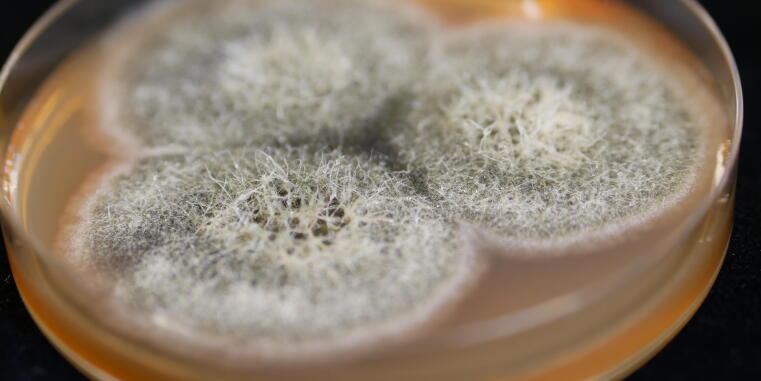
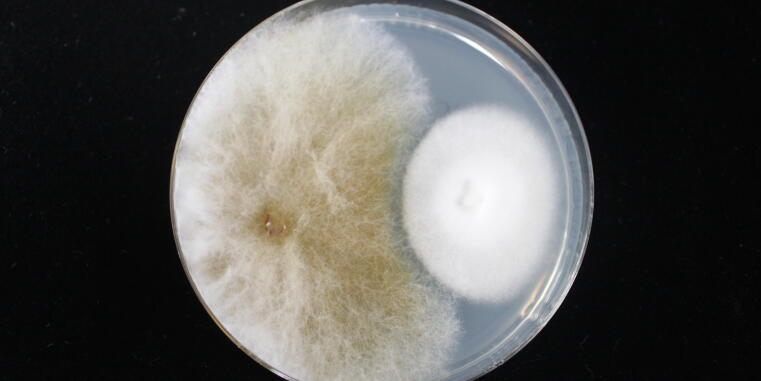

Meine Forschungsgruppe beschäftigt sich mit der Isolierung und Charakterisierung neuartiger Naturstoffe aus filamentösen Pilzen, darunter Gattungen wie Stachybotrys, Fusarium, Penicillium und Claviceps.
Pilze sind für ihre Fähigkeit bekannt, eine Vielzahl von Sekundärmetaboliten zu produzieren, die oft strukturell vielfältig und biologisch aktiv sind. Diese Verbindungen reichen von toxischen Mykotoxinen, die erhebliche Gesundheitsrisiken für Mensch und Tier darstellen, bis hin zu bioaktiven Molekülen, die in der Medizin Anwendung finden. Diese Doppelnatur macht unsere Forschung besonders relevant – sowohl für die Identifizierung neuer Mykotoxine als auch für die Entdeckung von Verbindungen mit potenziellem pharmazeutischem Nutzen.
Um neue und einzigartige Metaboliten zu entdecken, setzen wir verschiedene Strategien ein, darunter fortschrittliche Kultivierungstechniken, Gentechnik und (semi-)synthetische Methoden. Eine zentrale Innovation in unserem Labor ist die Entwicklung einer Mikro-Screening-Methode, die eine Pilzkultivierung in kleinen Volumina ermöglicht. Dieser Ansatz erlaubt eine schnelle, hochdurchsatzfähige Probenvorbereitung und direkte Analyse, ohne dass herkömmliche Extraktionsschritte erforderlich sind.
Das Institut für Lebensmittelchemie verfügt über modernste analytische Instrumente, darunter HPLC-HRMS- und MS/MS-Systeme, die wir für den Nachweis, die Identifizierung und die Struktureluizidierung von Pilzmetaboliten nutzen. In Zusammenarbeit mit mehreren Abteilungen der Medizinischen Chemie (Prof. Dr. Finn Hansen, Universität Bonn; PD Dr. Dmitrii Kalinin, Universität Münster) prüfen wir die biologische Aktivität der isolierten Verbindungen, um deren potenzielle Anwendungen in der Wirkstoffforschung zu erkunden.
Weitere Informationen zu unserer Arbeit finden Sie in unseren veröffentlichten Manuskripten (Link zu Manuskripten). Bei Interesse an unserer Forschung oder möglichen Kooperationen wenden Sie sich bitte an Dr. Svetlana Kalinina.